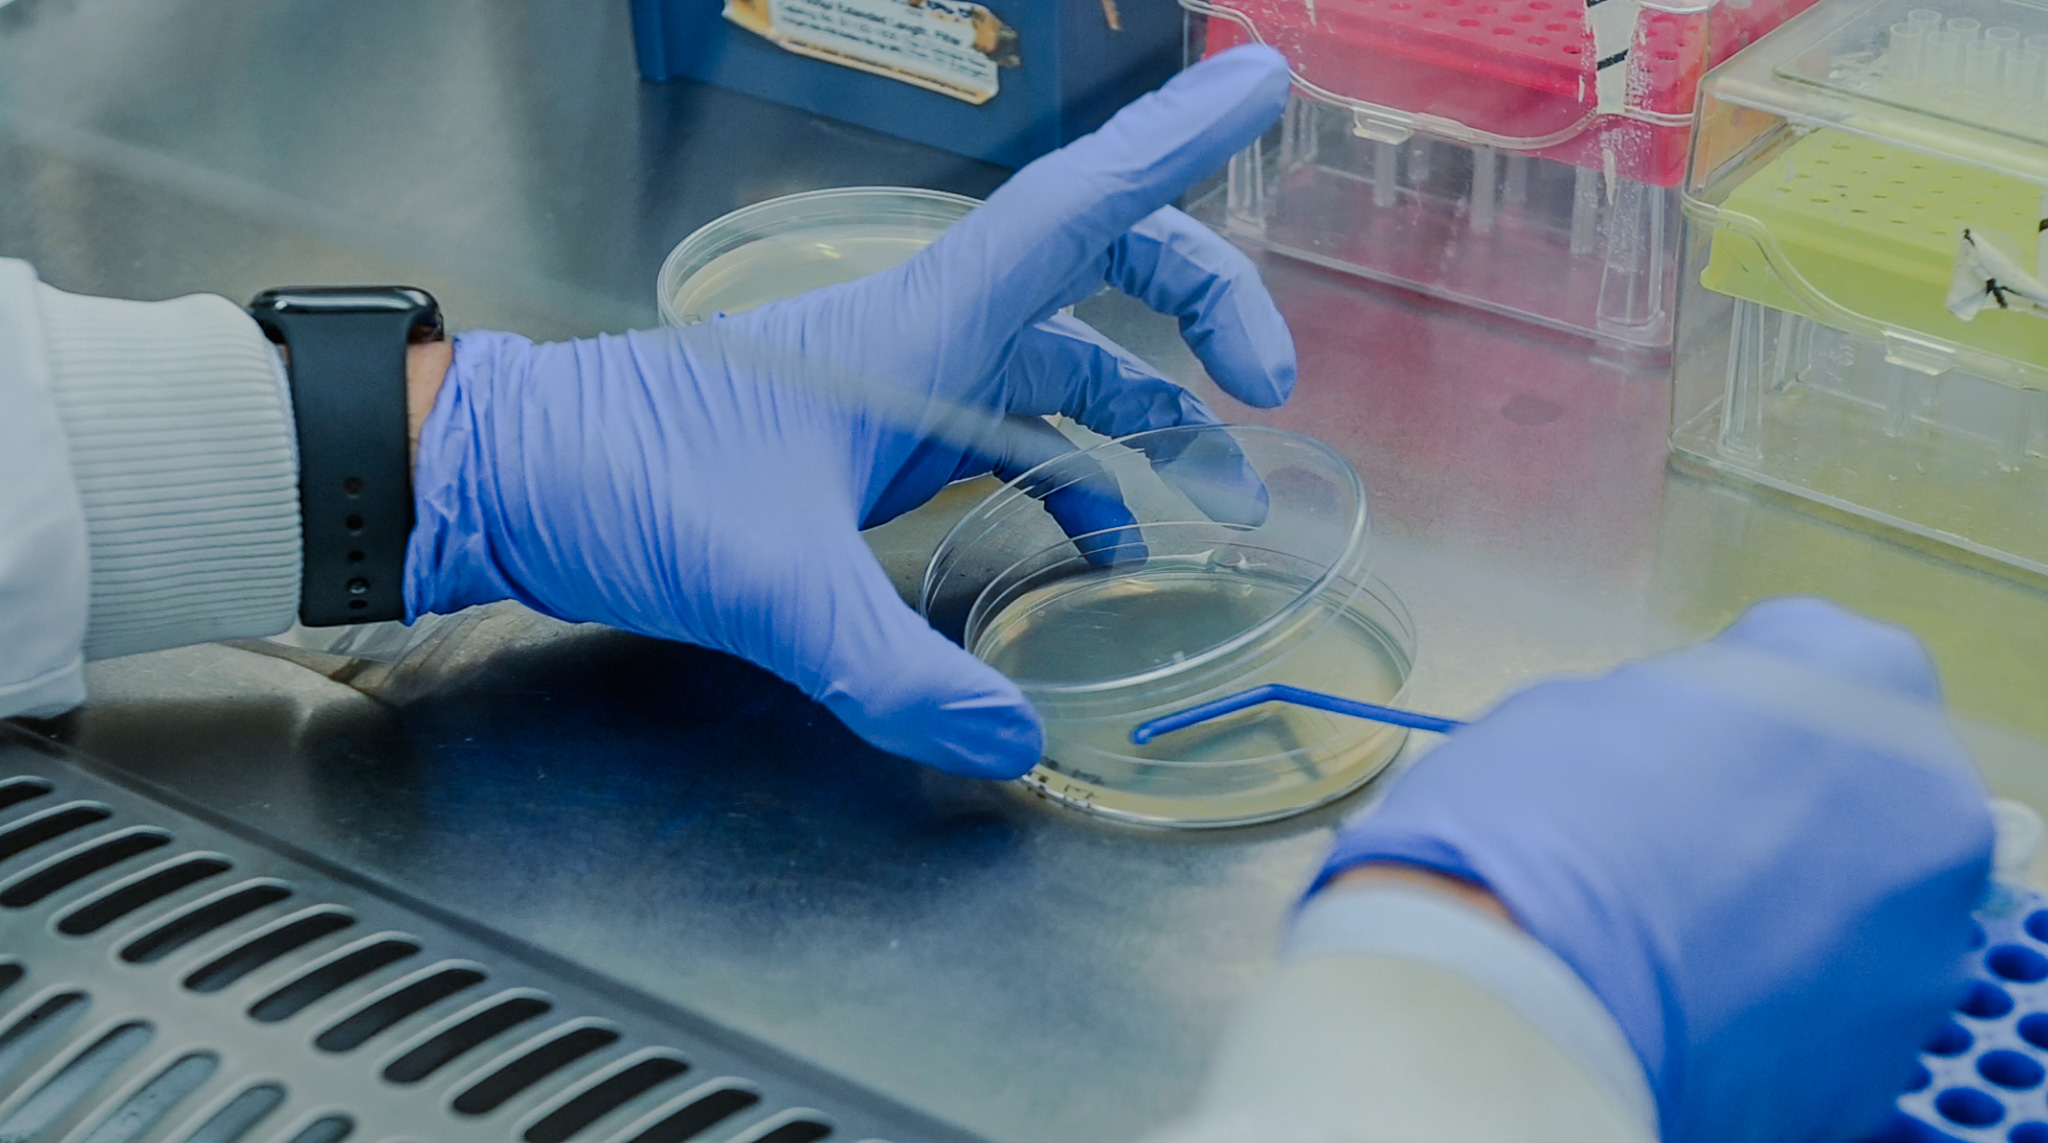
Green hydrogen research in the lab

Institute of Biomedical Engineering
Biomaterials and Biomechanics
Digital Health
Therapy and Drug Delivery
Neurotechnology
Tissue Engineering
Data Readiness
Beyond Antibiotics
Biomedical Image Analysis
Oxford Mechanobiology
Cerebral Haemodynamics Group
Bioelectronic Circuits and Systems
PULSE (Ultrasound)
Computational Health Informatics
Biomedical Image Analysis
Multimodal Medical Data Integration & Analysis
Healthcare Biorobotics Lab (HBL)
AI for Digital Health
COCHE
Communications Engineering
Oxford Secure Computer Architecture Research
Vectorial Optics and Photonics Group
Power Electronics Group
Computing Infrastructure
Optical Wireless Communications
Dynamic Optics and Photonics
Soft Matter Photonics
Information and Communication Networks
Oxford Metamaterials Network
Metamaterials Group
Optical Fibre Sensors
Energy and Power Group
ZERO Institute
Battery Intelligence Lab
Power Systems Architecture Lab
Power Electronics Group
Combustion and Engines (Thermal Propulsion Systems Research Group)
Oxford e-Research Centre
Energy and Environmental Informatics
Environmental Fluid Mechanics
Tidal Energy
Monroe Research Group
Cryogenic Engineering
Cryogenic Fluid Dynamics Lab
Data Readiness
Foerster Lab for AI Research
Oxford Secure Computer Architecture Research
Torr Vision Group
Machine Learning Research Group
Oxford e-Research Centre
Computational Health Informatics
Oxford Robotics Institute
Information and Communication Networks
Pierrehumbert Language Modelling Group
Healthcare Biorobotics Lab (HBL)
Information Engineering
AI for Digital Health
Solid Mechanics and Materials Group Website
Mechanics of Materials Group (Martinez-Paneda)
Oxford Mechanobiology
High Strain Rate Group
SEE – Sustainable Engineering and Entrepreneurship
Circular Economy and Sustainability Lab
Computational Mechanics
Fatigue and Fracture Mechanics
Impact Engineering
Materials Engineering
Micromechanics and Materials Modelling
University Technology Centre (UTC)
In-situ Microscopy and Analysis
Multifunctional Materials & Composites Lab
Brassart
Jerugroup
Quantum Device Lab
EMAM People
Oxford Thermofluids Institute
Combustion and Engines (Thermal Propulsion Systems Research Group)
Fluid Dynamics Lab
Particle Deposition Group
High Speed Turbomachinery Group
Turbine Cooling Group
Computational Fluid Dynamics Group
Active Flow Control Group
Hypersonics Group
High Heat Flux Cooling Group
Sustainable Aviation
Numerical Analysis Group
Cryogenic Fluid Dynamics Lab
No results found...
No matches found!
Oxford Mechanobiology
Cerebral Haemodynamics Group
Bioelectronic Circuits and Systems
PULSE
Computational Health Informatics
Biomedical Image Analysis
MultiMeDIA
Healthcare Biorobotics Lab
AI for Digital Health
COCHE
Institute of Biomedical Engineering
Biomaterials and Biomechanics
Digital Health
Therapy and Drug Delivery
Neurotechnology
Tissue Engineering
Data Readiness
Beyond Antibiotics
Biomedical Image Analysis
Oxford Green Ammonia Technology
Synbiosc
Sustainable Water Process Engineering
Systems Engineering
Membrane Science & Technology
Environmental Engineering
Chemical and Process Engineering
Tissue Engineering
Structural Engineering and Materials
Environmental Fluid Mechanics
Non-Linear Dynamics
Special Structures Group
Geotechnical Engineering
Ophthalmic Engineering
Civil and Offshore Engineering
Mechanics of Materials Group (Martinez-Paneda)
Control Group
Advanced Instrumentation Research Group
SySOS
Power Electronics Group
Computing Infrastructure
Optical Wireless Communications
Dynamic Optics and Photonics
Soft Matter Photonics
Information and Network Science Lab
Oximeta
Metamaterials
Optical Fibre Sensors
Communications Engineering
Oxford Secure Computer Architecture Research
Vectorial Optics and Photonics Group
Power Electronics Group
Thermal Propulsion Systems
Oxford e-Research Centre
Energy and Environmental Informatics
Environmental Fluid Mechanics
Tidal Energy
Monroe Research Group
Cryogenic Engineering
Cryogenic Fluid Dynamics Lab
Energy and Power Group
ZERO Institute
Battery Intelligence Lab
Power Systems Architecture Lab
SEE – Sustainable Engineering and Entrepreneurship
Circular Economy and Sustainability Lab
Machine Learning Research Group
Oxford e-Research Centre
Computational Health Informatics
Oxford Robotics Institute
Information and Network Science Lab
Pierrehumbert Language Modelling Group
Healthcare Biorobotics Lab
Information Engineering
AI for Digital Health
Data Readiness
Foerster Lab for AI Research
Oxford Secure Computer Architecture Research
Torr Vision Group
Oxford e-Research Centre
Oxford Robotics Institute
Institute of Biomedical Engineering
Oxford Man Institute
Oxford Thermofluids Institute
ZERO Institute
The Podium Institute
Oxford Mechanobiology
High Strain Rate Group
SEE – Sustainable Engineering and Entrepreneurship
Circular Economy and Sustainability Lab
Computational Mechanics
Fatigue and Fracture Mechanics
Impact and Shock Mechanics
Materials Engineering
Micromechanics and Materials Modelling
University Technology Centre (UTC)
LIMA
MMC Lab
Brassart
Jerugroup
Quantum Device Lab
EMAM People
Solid Mechanics and Materials Group Website
Mechanics of Materials Group (Martinez-Paneda)
Thermal Propulsion Systems
Fluid Dynamics Lab
Particle Deposition Group
High Speed Turbomachinery Group
Turbine Cooling Group
Computational Fluid Dynamics Group
Active Flow Control Group
Hypersonics Group
High Heat Flux Cooling Group
Sustainable Aviation Group
Numerical Analysis Group
Cryogenic Fluid Dynamics Lab
Oxford Thermofluids Institute